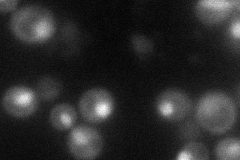
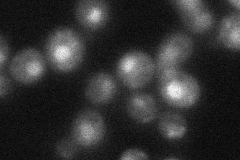
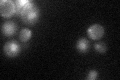

View description
Mitogen-activated protein kinase (MAPK) involved in signal transduction pathways that control filamentous growth and pheromone response; the KSS1 gene is nonfunctional in S288C strains and functional in W303 strains
Localization:
Intensity:
Fold change:
Significance:
-
C’ GFP library in SD

nucleus27.72 -
N' NOP1pr-GFP in SD
cytosol,nucleus60.5339 -
N' TEF2pr-mCherry in SD

nucleus85.7265 -
N' NATIVEpr-GFP in SD
nucleus33.3935 -
N' TEF2pr-VC and Cyto-VN in SD

#N/A0 -
C’ GFP library in SD+DTT

nucleus31.531.13No -
C’ GFP library in SD+H2O2

nucleus33.051.19No -
C’ GFP library in Starvation Media
nucleus43.591.57Yes -
C’ GFP library on the background of Pup2-DaMP

nucleus -
C’ GFP library on the background of CCT mutant

nucleus25.50180.919542No
